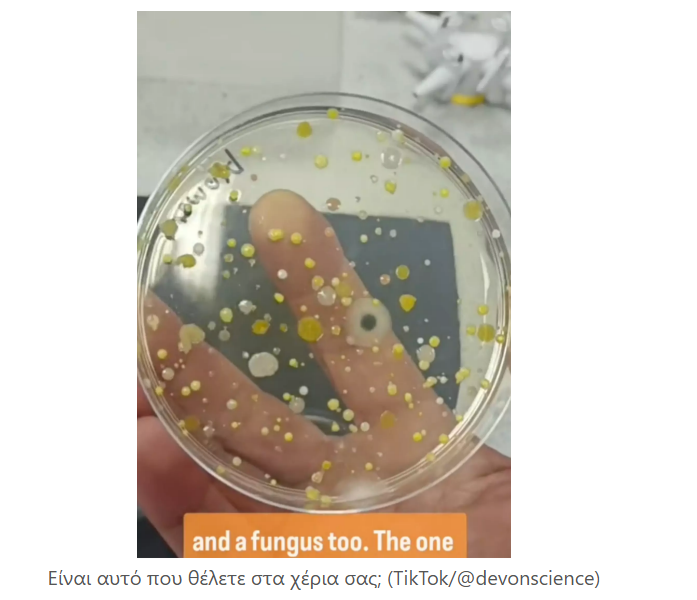

Μία επιστήμονας διεξήγαγε ένα αηδιαστικό αλλά σημαντικό πείραμα για τους στεγνωτήρες χεριών στις δημόσιες τουαλέτες. Πιθανότατα έχετε ακούσει προειδοποιήσεις για το ότι δεν είναι ιδιαίτερα καθαροί – αλλά τι επιλογές έχουμε πλέον;
Η πλειονότητα των δημόσιων τουαλετών έχουν αφαιρέσει τη δυνατότητα χρήσης χάρτινων πετσετών για το στέγνωμα των χεριών, στο όνομα της προστασίας του περιβάλλοντος – και δικαιολογημένα.
Αλλά τι μας μένει ως επιλογή; Δυστυχώς, κάτι αηδιαστικό.
Τα αποτελέσματα του πειράματος
Η επιστήμονας Ruth, γνωστή ως Devon Science στο TikTok, αποκάλυψε πόσο ανθυγιεινοί μπορεί να είναι οι στεγνωτήρες χεριών.
Σε ένα βίντεο που έχει γίνει viral με πάνω από 4,7 εκατομμύρια προβολές, η Ruth τοποθέτησε ένα τρυβλίο Petri κάτω από έναν στεγνωτήρα χεριών, αφήνοντάς τον να φυσήξει αέρα.
Στη συνέχεια, συνέλεξε αέρα από το εργαστήριό της και τα δύο πιάτα αφέθηκαν όλη τη νύχτα. Την επόμενη ημέρα, τα αποτελέσματα ήταν σοκαριστικά.
Το τρυβλίο που εκτέθηκε στον αέρα του στεγνωτήρα είχε αναπτύξει διάφορους τύπους βακτηρίων και μύκητες, σχηματίζοντας κίτρινες, μαύρες και λευκές κηλίδες. Αντίθετα, εκείνο που εκτέθηκε στον αέρα του δωματίου παρέμεινε εντελώς καθαρό.
@devonscience Urghh, don’t use a hand dryer😱🦠 —– Update: thank you for all your comments & suggestions. Totally blown away by how far this little video has reached 😮 I’m planning on doing some update videos on this experiment and will post on here, as well as on our FB & IG pages, which you are welcome to follow as well 😉 Thank you, Ruth (from Devon Science) #germs #publictoilet #bacteria #dirty #gross #justdont #scienceteacher #handwashchallenge #handdryer #science #scienceexperiments #microbiology #scienceproject #lesson #handdryer #handdryerbacteria
Είναι οι στεγνωτήρες η μόνη επιλογή;
Παρότι το να στεγνώνετε τα χέρια σας με κίνηση στον αέρα μπορεί να πάρει περισσότερο χρόνο, αποδεικνύεται πως είναι η πιο υγιεινή επιλογή.
Όσο για το χαρτί υγείας; Η Ruth δοκίμασε και αυτή την επιλογή σε άλλο βίντεο, τρίβοντας ένα πιάτο Petri με χαρτί υγείας. Αν και ανέπτυξε βακτήρια, αυτά ήταν πολύ λιγότερα σε σύγκριση με τον στεγνωτήρα.
Πηγή μόλυνσης
Για να ενισχύσει το συμπέρασμά της, η επιστήμονας σκούπισε το εσωτερικό του στεγνωτήρα με ένα βαμβάκι, το οποίο μαύρισε αμέσως. Τοποθέτησε το βαμβάκι σε τρυβλίο Petri, το οποίο ανέπτυξε παρόμοια βακτήρια με αυτά που φυσούσε ο στεγνωτήρας.
Η Ruth κατέληξε: «Τώρα ξέρω από πού προέρχονται τα βακτήρια – ζουν μέσα στη μηχανή.»
Παρόλο που δεν καθορίστηκε το ακριβές είδος των βακτηρίων, το θέμα φαίνεται ήδη ανησυχητικό.
Αντιδράσεις χρηστών
Οι χρήστες στα σχόλια μοιράστηκαν τις σκέψεις τους για τα αποτελέσματα. Ένας σχολίασε: «Αυτό που με τρομάζει είναι ότι εργάζομαι στην Δημόσια υγεία και μας αφαίρεσαν το χαρτί. Είμαστε υποχρεωμένοι να χρησιμοποιούμε τους στεγνωτήρες, ακόμη και οι κάδοι αφαιρέθηκαν για να μη χρησιμοποιούμε χαρτί υγείας».
Άλλος είπε: «Σταμάτησα να χρησιμοποιώ στεγνωτήρες χεριών αφού είδα αυτά τα βίντεο». Ένας τρίτος πρόσθεσε: «Ποτέ ξανά στεγνωτήρες χεριών».
Επιστημονική ανάλυση
Σε μια μικρή μελέτη του 2021, οι μισοί από τους συμμετέχοντες χρησιμοποίησαν χαρτοπετσέτες για να στεγνώσουν τα χέρια τους ενώ οι άλλοι μισοί χρησιμοποιούσαν στεγνωτήρα αέρα.
Στη συνέχεια οι ερευνητές ανέλυσαν τις ποδιές, τα χέρια των συμμετεχόντων και τις επιφάνειες που άγγιξαν μετά για να δουν πώς εξαπλώνονται οι ιοί.
Τα αποτελέσματα έδειξαν ότι οι άνθρωποι που χρησιμοποιούσαν στεγνωτήρια χεριών είχαν περισσότερους ιούς στα χέρια και στις ποδιές τους από αυτούς που χρησιμοποιούσαν χαρτοπετσέτες.
Αλλά είναι σημαντικό να έχουμε κατά νου ότι το πείραμα χρησιμοποίησε υψηλές ποσότητες μικροβίων που μπορεί να μη βρεθούν σε ένα μέσο περιβάλλον και ότι το μέγεθος του δείγματος ήταν πολύ μικρό.
Ωστόσο, αυτά τα ευρήματα ήταν παρόμοια με τα αποτελέσματα άλλων μελετών, συμπεριλαμβανομένης μιας μελέτης του 2018 που διαπίστωσε ότι τα στεγνωτήρια χεριών μπορούν να φυσήξουν τα βακτήρια που υπάρχουν στα δημόσια μπάνια στα χέρια σας.
Αν και αυτό δεν επιβεβαιώνει ότι τα στεγνωτήρια χεριών μπορούν να μεταδώσουν ορισμένους ιούς, ο Παγκόσμιος Οργανισμός Υγείας (ΠΟΥ) κατέστησε σαφές ότι τα στεγνωτήρια χεριών δεν μπορούν να προστατεύσουν από τον ιό COVID-19, όπως αναλύεται και στην Cleveland Clinic.
Μήπως ήρθε η ώρα να στεγνώνετε τα χέρια σας στον αέρα;